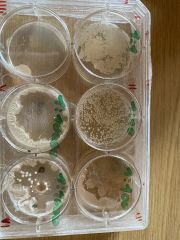

This special page shows all uploaded files.
| Date | Name | Thumbnail | Size | Description | Versions |
|---|---|---|---|---|---|
| 14:00, 4 January 2022 | 3dcollage.jpeg (file) |  |
216 KB | File uploaded with MsUpload | 1 |
| 09:27, 6 December 2022 | 5 olfactory art-.pdf (file) | 613 KB | File uploaded with MsUpload | 1 | |
| 13:21, 6 June 2022 | 6662222.jpeg (file) |  |
5.15 MB | File uploaded with MsUpload | 1 |
| 13:22, 6 June 2022 | 666b222.jpeg (file) |  |
3.23 MB | File uploaded with MsUpload | 1 |
| 13:28, 4 January 2022 | AdditionalEquipment.jpeg (file) |  |
191 KB | File uploaded with MsUpload | 1 |
| 11:22, 30 September 2022 | Aframe.JPG (file) |  |
6.07 MB | File uploaded with MsUpload | 1 |
| 13:28, 4 January 2022 | AirqualitySensor.jpeg (file) |  |
144 KB | File uploaded with MsUpload | 1 |
| 13:52, 29 March 2023 | AllesHochkant.JPG (file) |  |
769 KB | File uploaded with MsUpload | 1 |
| 13:52, 29 March 2023 | Alleslinks.JPG (file) |  |
1.8 MB | File uploaded with MsUpload | 1 |
| 13:52, 29 March 2023 | Allesreechts.JPG (file) |  |
2.7 MB | File uploaded with MsUpload | 1 |
| 09:02, 15 December 2021 | Anhang 1 (2).jpeg (file) |  |
2.24 MB | File uploaded with MsUpload | 1 |
| 11:23, 30 September 2022 | Armband.JPG (file) |  |
5.33 MB | File uploaded with MsUpload | 1 |
| 10:45, 30 September 2022 | Atriummmi.JPG (file) |  |
6.37 MB | File uploaded with MsUpload | 1 |
| 11:00, 30 September 2022 | BAhnhoff.JPG (file) |  |
6.31 MB | File uploaded with MsUpload | 1 |
| 10:57, 30 September 2022 | Baahnhof.JPG (file) |  |
5.87 MB | File uploaded with MsUpload | 1 |
| 10:58, 30 September 2022 | Backpack.JPG (file) |  |
5.92 MB | File uploaded with MsUpload | 1 |
| 10:59, 30 September 2022 | Backpack2.JPG (file) |  |
6.1 MB | File uploaded with MsUpload | 1 |
| 13:17, 30 May 2022 | Bacteriaa.jpeg (file) |  |
5.22 MB | File uploaded with MsUpload | 1 |
| 13:15, 30 May 2022 | Bacteriaaaa.jpeg (file) | |
2.63 MB | File uploaded with MsUpload | 1 |
| 11:01, 30 September 2022 | Barfusss.JPG (file) |  |
5.59 MB | File uploaded with MsUpload | 1 |
| 16:56, 28 June 2022 | Beautifulfailure.jpeg (file) |  |
2.1 MB | File uploaded with MsUpload | 1 |
| 13:28, 4 January 2022 | BreadBoard.jpeg (file) |  |
148 KB | File uploaded with MsUpload | 1 |
| 08:09, 5 July 2022 | CHhharness.jpg (file) |  |
150 KB | File uploaded with MsUpload | 1 |
| 14:05, 13 May 2022 | CONCEPT 130516 OCE UD.pdf (file) | 121 KB | File uploaded with MsUpload | 1 | |
| 09:14, 21 May 2022 | CONCEPT OCE 2005221UD.pdf (file) | 196 KB | File uploaded with MsUpload | 1 | |
| 11:21, 13 May 2022 | CONCEPT STAGE1305OCE UD.pdf (file) | 112 KB | File uploaded with MsUpload | 1 | |
| 21:30, 28 November 2022 | CONSEKT.jpeg (file) |  |
2.12 MB | File uploaded with MsUpload | 1 |
| 08:24, 5 May 2022 | Circutboars.jpeg (file) |  |
2.31 MB | File uploaded with MsUpload | 1 |
| 08:31, 5 May 2022 | Circutboarss.jpeg (file) |  |
2.31 MB | File uploaded with MsUpload | 1 |
| 13:52, 29 March 2023 | CloseUpSchrittbeide.JPG (file) |  |
1.99 MB | File uploaded with MsUpload | 1 |
| 14:40, 13 May 2022 | Cncptsht.jpg (file) |  |
138 KB | File uploaded with MsUpload | 1 |
| 15:53, 3 February 2022 | ColorTransscriptionDiagram.png (file) |  |
655 KB | File uploaded with MsUpload | 1 |
| 15:37, 3 February 2022 | Color Transscription Diagramm.jpg (file) | 3.4 MB | File uploaded with MsUpload | 1 | |
| 23:55, 6 February 2022 | Coloradjusting.jpeg (file) |  |
2.75 MB | File uploaded with MsUpload | 1 |
| 20:56, 6 February 2023 | Connectionpipess.jpg (file) |  |
179 KB | File uploaded with MsUpload | 1 |
| 12:54, 5 June 2022 | Coverr.jpeg (file) |  |
2 MB | File uploaded with MsUpload | 1 |
| 14:45, 6 July 2022 | Cutiingpattern3.jpeg (file) |  |
2.06 MB | File uploaded with MsUpload | 1 |
| 14:45, 6 July 2022 | Cuttingpattern1.jpeg (file) |  |
2.4 MB | File uploaded with MsUpload | 1 |
| 14:45, 6 July 2022 | Cuttingpattern2.jpeg (file) |  |
2.42 MB | File uploaded with MsUpload | 1 |
| 14:45, 6 July 2022 | Cuttingpattern4.jpeg (file) |  |
2.57 MB | File uploaded with MsUpload | 1 |
| 11:45, 4 July 2022 | DRessandHAens.jpeg (file) |  |
541 KB | File uploaded with MsUpload | 1 |
| 11:43, 13 June 2022 | Deadpp.jpeg (file) |  |
1.19 MB | File uploaded with MsUpload | 1 |
| 11:43, 13 June 2022 | Deadppp.jpeg (file) |  |
912 KB | File uploaded with MsUpload | 2 |
| 20:47, 6 February 2023 | Digisketch.jpg (file) |  |
90 KB | File uploaded with MsUpload | 1 |
| 11:19, 4 July 2022 | Dress.jpeg (file) |  |
3.41 MB | File uploaded with MsUpload | 1 |
| 11:19, 4 July 2022 | Dress1.jpeg (file) |  |
2.66 MB | File uploaded with MsUpload | 1 |
| 11:45, 4 July 2022 | DressandHArness.jpeg (file) |  |
562 KB | File uploaded with MsUpload | 1 |
| 09:31, 7 July 2022 | Dressssssss.JPG (file) |  |
6.34 MB | File uploaded with MsUpload | 1 |
| 11:21, 4 July 2022 | Earrings.jpeg (file) |  |
1.31 MB | File uploaded with MsUpload | 1 |
| 11:22, 4 July 2022 | Electronicsss.jpeg (file) |  |
2.07 MB | File uploaded with MsUpload | 1 |